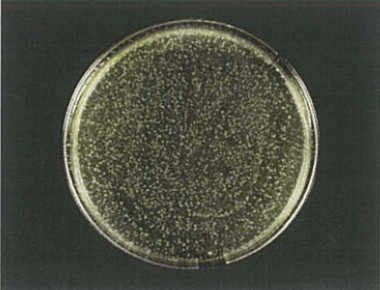

製品情報
Our Products


3つの酸素原子で構成されるオゾンは酸素に戻ろうとする性質があり、オゾンから放出された酸素原子は周囲のいろいろな物質と酸化反応を起こします。悪臭物質や有害な細菌と反応することで脱臭や除菌などの効果が得られるのです。

[試験条件:(財)日本食品分析センターによる殺菌効果試験報告書第397040615-001号参照]


製品に関するお問い合わせは「お問い合わせ」ボタン、もしくは下記までお気軽にどうぞ。
| ● 住環境業務部 | 〒448-0021 刈谷市八軒町1丁目8番地 TEL : (0566) 25-1490、1827 FAX : (0566) 25-1966 mail : |
|---|